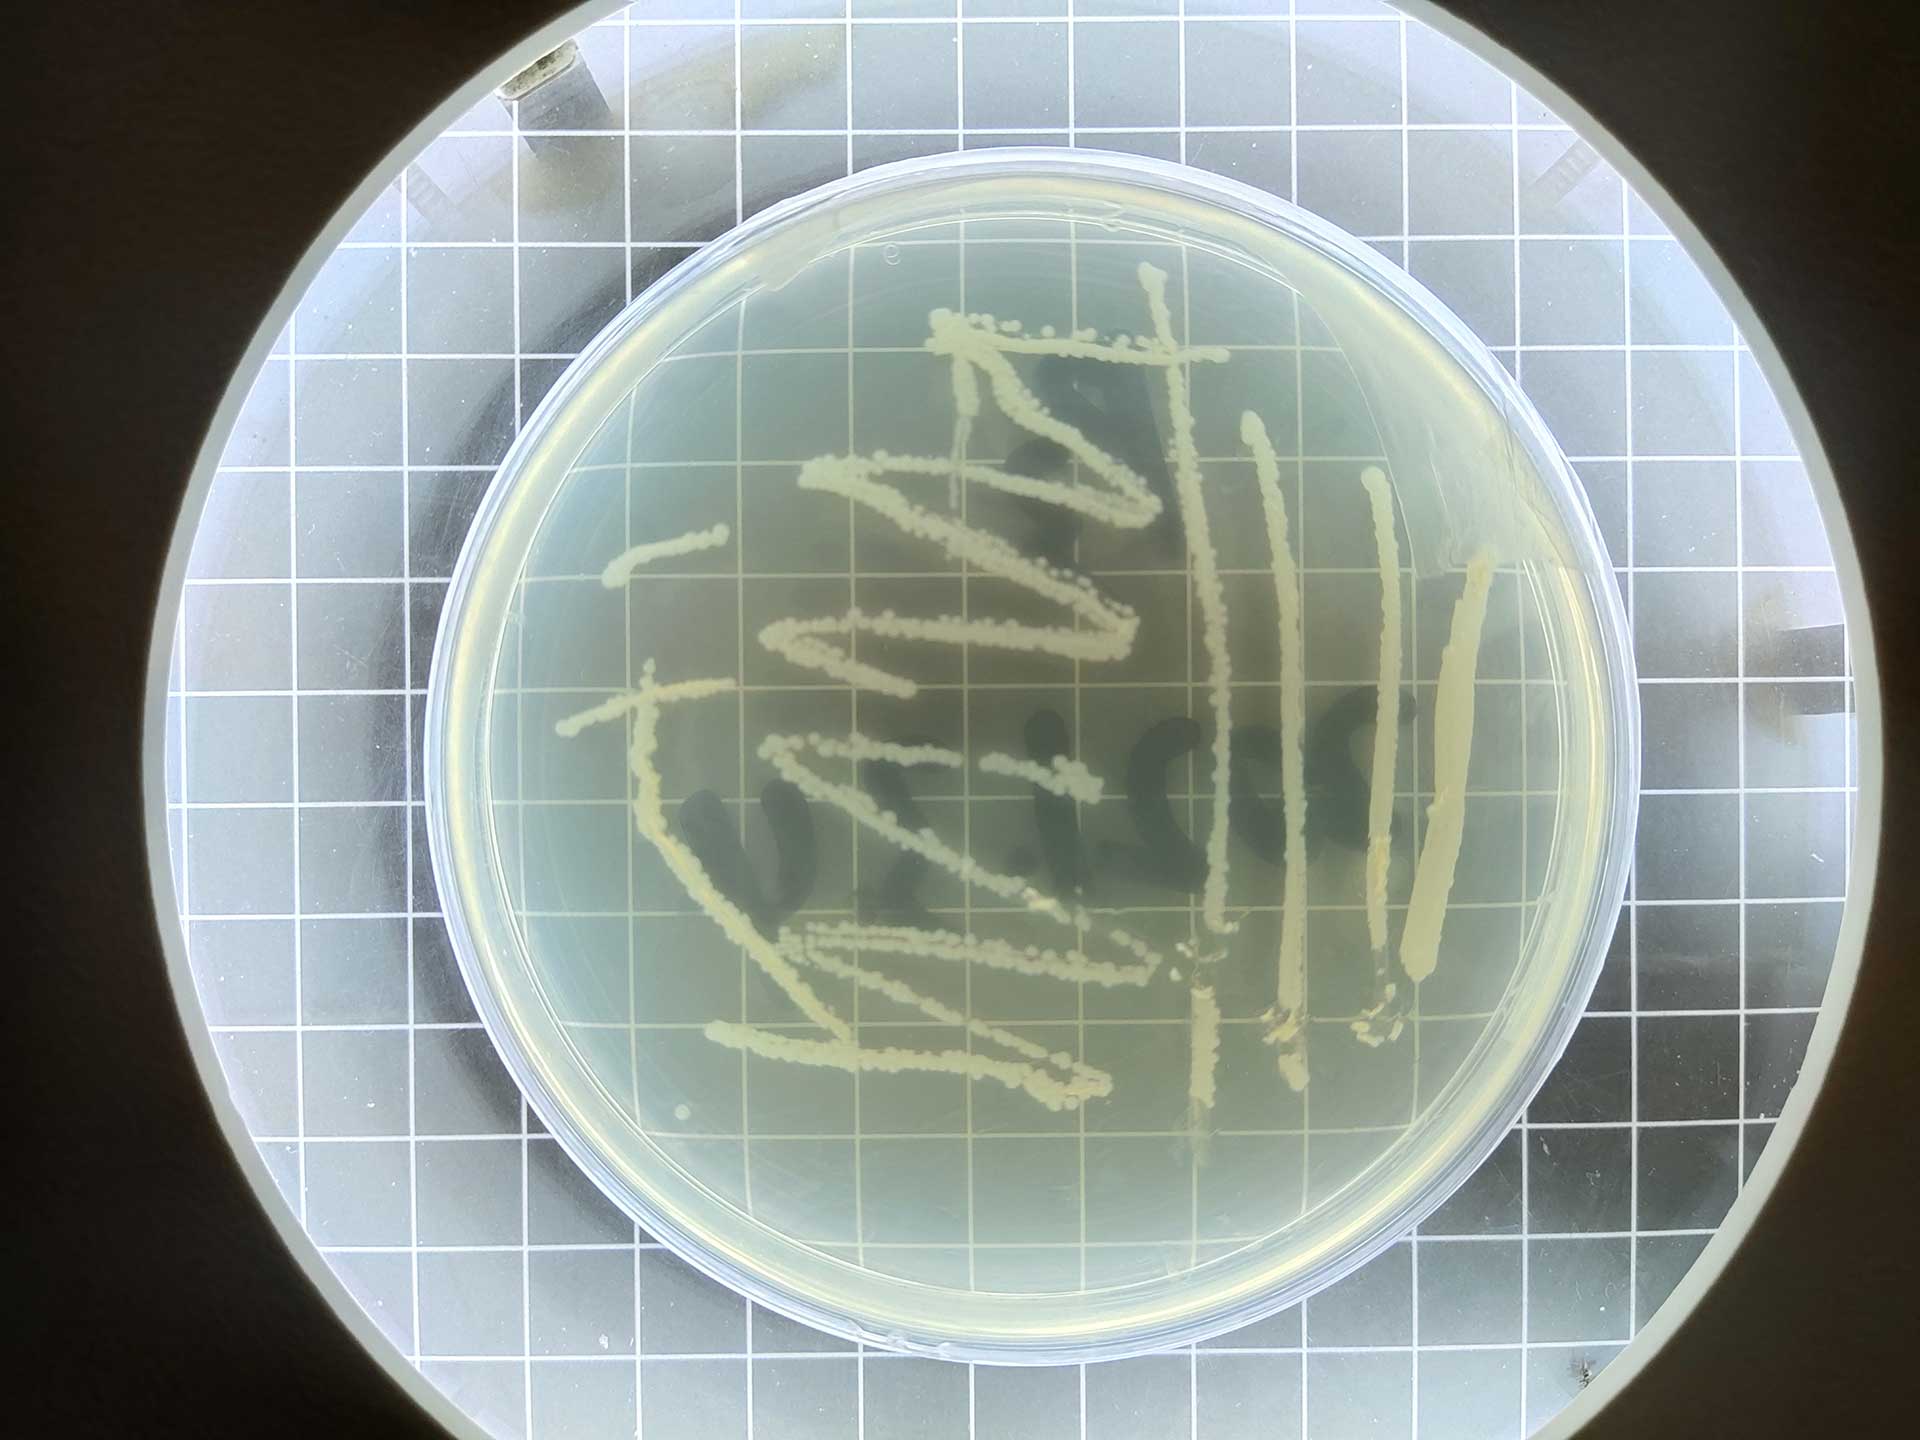

企业背景
早在2012年中央一号文件公布“把农业科技摆在更加突出的位置”文件指出:着眼长远发展,提前部署前沿技术和基础研究,力争在农业科技前沿领域占有重要位置,面向产业需求,着力突破农业重大关键技术和共性技术,文件还强调:大力推进现代农业产业技术体系建设,完善以产业需求为导向,以农产品为单元,以产业链为主线,充分发挥技术创新,实验示范带动的积极作用。实现农业持续稳定发展,确保农产品有效供给,根本出路在科技,农业科技是确保国家粮食安全的基础支撑,是突破资源环境约束的必然选择,是加快现代化农业建设的决定力量,坚持科教兴农战略,把农业科技摆在更加突出的位置,推动农业科技跨越发展,为农业增产、农户增收、农村繁荣注入强劲动力。
而作为科技兴农的其中一个重要的组成部分就是肥料的使用,用科技改变几十年的传统大化肥的使用造成的土壤板结、农作物品质下降、环境污染等等问题,也是有必要的。在此背景下,沣田宝农业科技有限公司在2014年应运而生,以科技创新为初心,站在农业发展的新起点,用科技创新服务于农业,用技术造福于农业,用成果发展于农业的功能性生态肥料的先锋企业,同时也是一家开展土壤微肥技术研发创新的企业。
企业基本情况

沣田宝农业科技有限公司于2014年1月6日在国家工商总局注册,公司初始投入资金5000万元,是位于国家农业园区内的农业技术企业,总占地面积12万余平方米,经过发展资产总投入2.8亿元,是集科研、生产、销售、仓储、物流、农化服务为一体的国家级高新技术企业。
公司引入阿米巴管理体系,配自创的“以客户为中心”的(CFT+3S)标准化服务体系,把企业架构中的生产、研发、销售、市场服务等部门划分为众多独立核算、自主经营的利润核算单元,能在降低成本的同时,做到精准服务于市场。公司形成了以肥料、微肥、特肥制造、菌剂研发制造、土壤改良、盐碱地治理、液体固体粪污高效处理、种养结合为一体的综合性农业科技企业。在公司独有的三大核心技术的基础上,自主创新的“1+1+1+5”的退役军人创业模式、“掏宝还田”人居环境治理合作商模式及“363”果菜粮微肥套餐专卖模式,通过三个独特创新的市场运作模式,公司目前形成了以沣田宝农业科技有限公司为中心,下设河北丰领冠环污治理发展有限公司、新疆沣田宝农业发展有限公司(北疆)、巴州沣田宝土壤修复技术开发有限公司(南疆)、河北沣田宝生物科技有限公司、玉田县海成货物运输有限公司及四个年总处理能力400万方的粪污处理分公司,并承担着玉田县19万户人居环境项目运营,已面向全国县区进行技术复制。

目前公司已经确立了稀土螯合技术、高嗜热菌技术和土壤改良技术为企业的三大核心技术,在三大核心技术的基础上定位于六大系列产品方向和市场推动模式,衍生四十余种产品并在国内外的市场占有一定地位。
公司本着“以客户为中心、为客户创造价值”的宗旨,以“改良土壤,节本提质”为初心,技术不断创新、升级,致力于把绿色肥沃健康撒遍中国大地,成为用科技服务于农业,用技术造福于农业,用成果发展于农业的功能性生态肥料的企业。
分公司基本情况
1.河北丰领冠环污科技发展有限公司

河北丰领冠环污科技发展有限公司成立于2015年,以土壤改良剂、环保设备组装、有机肥及微生物肥料、除臭剂技术研发、生产、推广及销售为主营业务,2020年承接了玉田县19万户人居环境治理项目,解决了“厕所革命”中变废为宝的终端技术问题,并在2021年,吸引了全国各地团队及政府相关部门进行参观,有望2022年,达到全国推广复制。
2.四个粪污处理分公司
 为解决人居环境及畜禽粪污污染问题,公司成立了玉田县凯盛农业有限公司、玉田县亮甲店粪污处理有限公司、玉田县润巨农业有限公司和玉田县通文农业有限公司四个年总处理能力400万方的粪污处理分公司,公司引进国外先进技术,经过技术研发中心的技术提升,培养优质发酵菌种,在人居环境及畜禽粪污处理技术上取得了技术突破,有效解决了人居环境及畜禽粪污变废为宝的终端难题。公司承接了玉田县大部分规模以上养殖场粪污发酵处理工作,与北京同仁堂玉田分公司、优然牧场等企业达成了深度合作。在技术上,公司通过与中国科学院、华北理工大学等高等院校的合作,为总公司生产有机肥提供了原料保证。
为解决人居环境及畜禽粪污污染问题,公司成立了玉田县凯盛农业有限公司、玉田县亮甲店粪污处理有限公司、玉田县润巨农业有限公司和玉田县通文农业有限公司四个年总处理能力400万方的粪污处理分公司,公司引进国外先进技术,经过技术研发中心的技术提升,培养优质发酵菌种,在人居环境及畜禽粪污处理技术上取得了技术突破,有效解决了人居环境及畜禽粪污变废为宝的终端难题。公司承接了玉田县大部分规模以上养殖场粪污发酵处理工作,与北京同仁堂玉田分公司、优然牧场等企业达成了深度合作。在技术上,公司通过与中国科学院、华北理工大学等高等院校的合作,为总公司生产有机肥提供了原料保证。
3.新疆沣田宝农业发展有限公司
新疆沣田宝农业发展有限公司成立于 2019年,以“动力源素”、水溶肥、叶面肥、土壤改良剂等产品的销售及市场开发服务为主营业务,针对土壤改良和盐碱地治理,公司技术研发中心在新疆石河子地区进行了大量实验,进行数据的整理和分析,摸索出适合新疆土地改良的技术和产品,获得了当地老百姓及政府的认可。
4.巴州沣田宝土地修复技术开发有限公司

5.河北沣田宝生物科技有限公司

6.唐山沣田宝微生物菌剂有限公司

起温快:在温度0℃以上时,24-48小时温度升至55℃以上,高温持久(可达5-8天)。发酵快,除臭效果好:可充分降解畜禽类粪便等有机物料中产生臭味的硫化合物、氮化合物、烃类、含氧有机物等,升温2-3天即可消除臭味,7-15天完全腐熟。
无害化程度高、养分高效:能有效杀灭发酵物料中的病原微生物、寄生虫卵、杂草种子。堆肥过程中总养分损失少,成熟物料养分增加明显。液体粪污发酵一般15天完全腐熟,固体粪污一般7天完全腐熟。
7.玉田县海成货物运输有限公司

玉田县海成货物运输有限公司成立于2019年,公司主要从事道路普通货物运输、大型货物道路运输等,拥有2-30吨车源30余台,大件车型40-100吨20余台,可调度车辆近200余台,并配有超过1000平方米的标准大型仓库为客户仓储。公司拥有一批年轻、充满朝气与活力的精通信息化管理的员工队伍。两年来,为打造“年轻化、信息化、品牌化”物流服务提供了智力支持。公司一直以科学的管理、专业的规范化服务,合理的运输价位、良好的企业信誉活跃于我国物流行业之林承揽公路货物运输。
公司九大中心、阿米巴管理商学院职能
1. 市场营销中心
 市场营销中心是相对于制造中心、研发中心而存在的,营销中心与研发中心、制造中心构成了企业的铁三角,既有分工又相互配合,研发是因,生产是果,营销贯穿于整个过程,既是因又是果。承担公司产品销售;承担市场信息调研;承担组织招商会;承担技术服务;承担客户开发;承担营销团队建设;承担客户档案建立;承担产品质量监督。
市场营销中心是相对于制造中心、研发中心而存在的,营销中心与研发中心、制造中心构成了企业的铁三角,既有分工又相互配合,研发是因,生产是果,营销贯穿于整个过程,既是因又是果。承担公司产品销售;承担市场信息调研;承担组织招商会;承担技术服务;承担客户开发;承担营销团队建设;承担客户档案建立;承担产品质量监督。
2. 购销中心
购销中心是公司产品或者服务的实际使用者、购买决策影响者、实际购买者、购买决策制定者以及购买信息的控制者。公司购销中心职能为负责部门人员的队伍建设,对采购员及统计培训企业文化及业务流程;负责制定本部门年月计划,对直接下级进行分解;不断拓展供应商渠道,坚持货比三家的原则,进行性价比,并议价在一家进货;对供应商进行管理,评价出合格供应商序列,做好备用供应商准备工作,并电子版留存;做好供应物料的统计工作,掌握当日物料库存品种、数量;及时上报主要原料市场走势,为公司决策提供依据;对直接下级进行年月日工作计划安排,及日工作落地卡考核评价;负责满足各中心对本中心提出的合理要求;负责进场原料质量把控,控制部门预算,降低费用成本;ERP系统的审批;负责采购物品质量问题的跟踪和处理。
3. 技术研发中心

技术研发中心的使命是为企业发展提供技术储备,寻找新的经济增长点,从企业发展的长远利益出发,为提高企业国内外市场竞争能力、增强企业发展后劲提供有力保障。技术研发中心在技术总监和各个专业经理的带领下,组建了研发团队和质检部,共同把控技术和产品质量,确保产品的效果和质量。负责本中心的团队建设,编写标准化手册并培训;负责制定本中心年、季、月度工作计划并执行;负责本中心档案整理和存档;负责控制本中心费用和设备设施维护;负责公司各中心送检样品的检测和结果分析;负责公司肥料的外检和各质量监督部门的抽检工作;负责各种肥料企业标准的起草和申报;负责各种肥料证件的办理和续展;负责药品库的管理;负责新产品的研发;负责产品质量监督和问题分析;负责包装和宣传彩页的审核;负责本中心数据管理和审批;负责解决各中心对本中心提出对合理要求。
4 . 生产制造中心

5. 行政人事中心

行政人事中心作为公司的管理与服务职能部门,负责建立和完善行政人事部的工作程序、岗位职责,使部门工作更加灵活高效,同时规范明晰部门日常工作。主要职能为负责本中心团队建设及人员培训工作;负责制定本中心年度工作计划和总结;负责配合公司进行企业文化建设;负责薪酬福利和绩效管理工作;负责制定、完善、监督、执行公司的各项管理制度;负责组织实施人员招聘、员工关系工作;负责公司对外联络、沟通协调工作;负责组织公司会议,协助组织公司重大活动;负责公司后勤管理保障工作;负责公司资料、信息和宣传报道的管理工作;负责公司公务车辆的管理调度工作;负责公司各种证照的办理工作;负责解决各中心对本中心提出的合理要求。
6. 财务管理中心

财务管理中心集资金运筹、会计核算、预算控制、成本管理为一体,根据管理的需要,将其职能进一步划分为财务管理、资金管理及会计核算三部分。财务管理是对企业生产经营中所需资金的筹集、投放、运用和分配以及贯穿于全过程的决策谋划、预算控制、分析考核等所进行的全面管理。具体职能为:遵守公司规章制度;负责组织本部门的团队建设,带领本部门编写标准化手册及培训;负责健全财务管理制度,编制财务计划;负责公司日常财务核算,参与公司的经营管理;编制记账凭证和各类报表,妥善管理会计账册档案;负责分析财务计划的执行情况并提供财务分析报告;负责设计公司内部控制制度,做好各项审计工作;负责企业年度财务决算工作,并进行综合分析;负责本企业税收管理和纳税筹划工作;负责公司资金运作情况,合理调配资金;负责对公司全部资产进行有效控制和管理;负责公司各种费用的审核及报销工作;负责有效、合理的使用资金;负责根据单位资金情况做好融资工作;负责解决各中心对本中心提出的要求。
7. 运营中心
为扩展公司的销售渠道,公司设置了运营中心,主要负责市场管理推动动力源素模式;负责市场管理推动人居环境模式;负责“363”果菜粮微肥套餐专卖模式内容细化;负责建立客服管理标准体系;负责建立网站建设、媒体、短视频宣传体系;负责创新创意、文案、设计体系;负责完善各种会议销售、推广体系;负责建立企业资料库、数据库管理。
8. 盐碱地治理中心

在2018年,公司针对盐碱地使用情况进行了的大量调研,发现我国拥有5.5亿亩可开发利用盐碱地,市场前景广阔。为此,公司投入大量资金,引进了国外先进的专利技术。结合中国科学院、中国农业大学、天津大学、华北理工大学进行了技术提升。公司技术研发中心在全国十几个省市进行了近千次的实地实验,采集了十几万个土壤数据,产品广泛应用到了油葵、棉花、水稻、谷子、玉米等作物,得到了河北张家口阳原县、沧州市南大港区、吉林省白城、蒙东通辽、蒙西巴彦淖尔、北疆石河子、南疆库尔勒、浙江省舟山等广大用户的认可。并在第五届“河北省农村创业创新项目创意大赛”中荣获一等奖。摸索出适合中国本土盐碱地治理的技术和产品。
9. 蛋白桑产业发展中心

为了有效利用可开发盐碱地,公司引进了中桑科技的优质耐盐碱桑树品种,并与中桑科技合作,在2019年建立了广西1000亩种苗基地、丰润500亩种苗基地,每年可对外输送优质种苗3亿株。2020年在玉田推动蛋白桑种植,得到了丰硕成果,比种植玉米、小麦的亩效益增长500元—1500元。作为饲料,可替代50%的玉米、豆粕等,比普通饲料原料成本降低25%左右。采用项目公司+示范基地+种植农户的经营模式,由公司统一育苗、统一种植计划,统一安排采割、运输,并组织专业技术人员培训到户,服务到地头。种植户只需按时浇水、施肥、精心管理。种植蛋白桑不仅增加农民收入,还可以推动地方生态农牧产业发展,延伸茶叶、挂面、蛋白桑鸡蛋、蛋白桑羊肉、蛋白桑猪肉等深加工,具有很高的经济效益、环保效益。
10. 阿米巴管理商学院

公司引入阿米巴管理体系,配以独创的“以客户为中心”的(CFT+3S)标准化服务体系,把企业架构中的生产、研发、销售、市场服务等部门划分为众多独立核算、自主经营的利润核算单元,能在降低成本的同时,做到精准服务于市场。
三大商业模式
为适应公司发展需求,带动三大技术的推广,设定了三大模式
1.“掏宝还田”人居环境治理
最近几年有分析人士指出,中国以占世界9%的耕地用去了世界1/3化肥,单位面积用量是世界平均水平的3.7倍,而每公斤养分所增产的粮食却不及世界的1/2,且肥料消费每年仍呈上升趋势。每年有超50亿吨的有机弃物不能很好的利用,环境生态压力很大,所以,依靠技术加强新型肥料的研发推广,是保障粮食安全、提高肥料利用率、减轻环境风险的重要途径。
在2018年中央1号文件明确要求,实施农村人居环境整治三年行动计划,以农村垃圾、污水治理和村容村貌提升为主攻方向,整合各种资源,强化各种举措,稳步有序推进农村人居环境突出问题治理。坚持不懈推进农村“厕所革命”,大力开展农村农户用卫生厕所建设和改造,同步实施粪污治理,加快实现农村无害化卫生厕所全覆盖,努力补齐影响农民群众生活品质的短板。农村垃圾、污水治理不仅是落实乡村振兴战略的需要,更是生态文明建设的需要,也是实现绿水青山就是金山银山的需要。


在2019年时,唐山市政府大力度推进人才科创项目引进,大力促进科技成果转化和高新技术产业发展,从韩国生命工学研究院引入了这项技术,经过我们企业积极争取,最后决定把这项技术授予我们沣田宝农业科技有限公司,然后公司的研发中心结合中科院、中国农业大学等技术院校对该技术经行技术升级,植入了与德国威廉瑞森(Weilan Reisen)公司合作研发的纳米增氧曝气机组。利用高速曝气盘,将液体有机物料中的离子打成纳米级,使其能够与氧气充分溶解,解决了氧气和水难容的问题,使高嗜热腐熟剂在发酵过程中获得足够的氧气,具备发酵的条件。经过35-40天,就能把这种臭烘烘的液体变成了无味儿的一种富含菌群,富含营养的液体肥。治理效果展现为:
(1)畜禽粪污处理(牛、马、猪、鸡等):固体粪污:传统处理发酵期为45-60天。目前处理发酵期为30天完全腐熟。液体尿液:传统无法处理成有机肥料(当做废水处理)。目前处理发酵期为35天完全腐熟。
(2)人居环境粪污处理:固体粪污:传统处理发酵期为45-60天。目前处理发酵期为30天完全腐熟。液体尿液:传统无法处理成有机肥料(当做废水处理)。目前处理发酵期为35天完全腐熟。
治理优势为:处理过程全程无污染,“零”污染排放;处理周期短、处理能力强;处理成本低、费用低、处理粪污更加彻底;处理后的粪污尿液,农户接受度高;通过我们已有相关成熟的技术,在2020年我公司承接了玉田县人居粪污第三方运营项目,承接全县20个乡镇及全县197350户人居粪污的,规范化收运、无害化处理、资源化利用等工作,年处理量高达400万方。
2.帮扶带退役军人“1+1+1+5”创业模式
在2016年时,我们企业的董事长陈铁成在看到国务院印发的《土壤防治行动计划》中明确指出“土壤防治要以保障农产品安全和人居环境健康为出发点,发挥市场作用,引导公众参与!”自此,陈铁成董事长认真领会内容,开始关注土壤改良等相关科技技术。恰逢时机,在2019年时,唐山市政府大力度推进人才科创项目引进,大力促进科技成果转化和高新技术产业发展,从韩国生命工学研究院引入了这项技术,经过我们企业积极争取,最后决定把这项技术授予我们沣田宝农业科技有限公司,随后农业农村部都在一直关注、跟进及大力支持着,通过2019-2021年这三年的种植实验及大面积农户使用情况,见证了其效果完全属实,能达到农作物增产增收、盐碱地改良,提高传统肥料的吸收率,解决土壤板结等等的重大难题。在2021年对该技术进行线上评审,得到一致好评,授予了我们陈铁成董事长“全国农村创业创新优秀带头人”的荣誉,更加坚定了我们企业对于推动土壤改良的信心。


在2021年10月份时,我们企业的陈铁成董事长在参加其孙子的满月宴时,同时还到场了十多名朝气蓬勃的退役军人,原因是陈董事长的儿子是一名退役军人,早在2013年陈董事长就把心爱的儿子送到部队接受党的教育与引导。在和这些退役军人聊天中了解到,政府一直积极的在帮助他们解决就业问题,同时他们还有很多想创业的想法。随后陈董事长的儿子陈月锋和陈董事长提及能不能企业也促进一下退役军人创业的事项。陈董事长备受感动,非常支持陈月锋的想法,同时也能帮助到退役军人,也能间接减轻政府相关部门的些许压力。
陈董事长在回到企业的第一时间,召开高层会议,要求结合当下“乡村振兴”的路线,培养乡村人才,快速助推“乡村振兴战略”。同时要求制定的方案中,扶持的创业团队及创业人员,全部在退役军人中选拔。经过企业高层一个月反复论证及磋商,为退役军人专门制定一套“1+1+1+5”创业模式。即“一个县区、一个目标(防治土壤污染)、一支创业团队、五名创业人员”方案。经过开会表决通过。
公司决定,由企业出资5000万元,全部用于购置土壤改良设备,推动“1+1+1+5”创业模式落地,争取在一年的时间内完成扶持1000支创业团队,6000名创业人员。同时会对所有有意向创业的退役军人进行免费的创业指导。
对创业人员条件标准为:必须是退役军人;有创业意向,愿为乡村振兴助力的退役军人; 参加“我为退役军人办实事”为主题的推介会,填写意向申请表后,经工作人员实地审核通过的退役军人。
具备符合创业团队标准的人员,全额支持158800元的创业设备一套。想和企业共同推动“1+1+1+5”的人员,只要符合企业相关部门条件,安排岗位共同助力“乡村振兴”。对此没有想法,还想创业的人员,可以免费参加3-5天的创业培训指导,奠定基础,便于自主创业。
“要想乡村振兴,必先人才振兴”通过沣田宝农业科技多年的发展经验结合中国农业大学、华北理工大学、天津大学等等的专家、科研及教学机构,对创业的退役军人进行:先进的技术支持体系、标准化的管理体系、标准化的培训体系、标准化的赋能体系的培养,四大体系倾囊相授必定实现“动力源素 百万起步” 。
3.“363”果菜粮微肥套餐专卖模式
目前我国的化肥国产化程度不断提高,化肥品种日益丰富。众多新型肥料品种的诞生,不仅使中国化肥产品结构发生巨大的变化,让农资行业营销模式发生改观,更改变了中国农民千百年来的耕地施肥模式。


稀土多元素螯合技术产品与大、中、微量元素、氮、磷、钾等不同用量配比,所形成的复混(合)肥填补并完善了目前全国所有品牌化肥作用的短板和空白,不但实现作物全生育期对各种养分的供应吸收,而且表现出抗倒、抗旱、抗寒、抗病、品质优、产量高。
现如今的肥料市场竞争可以用混乱来形容,各个厂家不论大厂小厂,为了市场份额,都使出了十八般武艺,所以出现在一个乡镇有十几家经销商销售肥料,恶性竞争,不但送货上门,而且可以赊销,造成单个门店都赚不到钱,生意越来越难做,老百姓购买肥料,据调查80%的人都是在经销商的介绍下购买的,经销商说哪个好,老百姓就买哪个肥,老百姓属于墙头草,随风倒,看别人买什么肥自己也买什么肥,而老百姓需要的是真正的好肥料,而不是忽悠人的东西,只要是好肥料他们愿意多投入多打粮食。作为连接肥料与种植户的纽带,公司销售人员都能吃苦耐劳,兢兢业业的工作,为了能多销售更多的肥料产品,与种植户搞好客情关系,努力发现客户潜在需求,满足其愿望,争取给广大经销商、种植户解决有价值的信息和任何问题。只要我们的产品能给种植户带来真正的实惠,只要我们的销售人员能为老百姓解决了实际问题,农户还是非常愿意使用我们的高科技产品。
正是由于农资市场目前的现状,所以我们开发了一套新型的销售模式,以技术服务为依托,“以客户为中心”的(CFT+3S)标准化服务体系,做到精准服务于经销商及农户。将在全国每个县区布局布点,建设服务团队,依托企业自有研发中心、研发团队及农化服务专家,真正的将服务落实在实处,真正的解决老百姓需要的问题,再将通过采集当地土壤样品进行化验,再结合技术衍生的富含18种微量元素的有机肥、复合(混)肥、菌剂等等四十余款产品,组合成针对农作物改良土壤、增产增收、提高农作物品质的专属套餐、专用肥。做到当年使用当年见效果,并且效果十分显著,得到广大经销商及农户的高度认可。
公司技术
公司以把绿色、肥沃、健康撒遍中国大地,成就员工、造福客户、回报社会为共有愿景,以自信、执著、锲而不舍,让不可能成为可能,让可能成为一定能为企业精神,在董事长以利国利民,为农产品产业链造福的理念指引下,在全体员工的奋力拼搏下,通过短短几年时间的市场竞争洗礼,针对当前行业发展趋势及当前土壤问题,我们公司依靠3大技术,已孵化出6大产品系列。三大技术为稀土螯合剂技术、高嗜热菌剂技术和土壤改良剂技术,六大系列产品为复合肥系列、水溶肥系列、有机肥系列、微生物菌剂系列、盐碱地系列和动力源素系列,针对不同土壤和不同作物的需求,公司现有产品四十余种,能够满足客户产品及技术升级需求。
1.稀土螯合技术
稀土多元螯合技术是利用元素间的协同作用和拮抗作用原理,将稀土有各种植物所需矿物元素进行螯合而成的肥料增效剂。稀土多元螯合剂特有的有机酸解决了土壤中金属元素不易溶于水吸收利用率低的难题。特有的稀土有益元素利用螯合工艺解决了金属元素溶于水后发生拮抗反应的问题,大大提高了元素的吸收利用率。稀土螯合技术分为两大系列产品:复混肥系列和水溶肥系列。公司研发了两种稀土螯合剂,一种非水溶性稀土螯合剂,用于加入复合肥、有机肥等肥料中,大大提高养分的吸收利用率;一种水溶性稀土螯合剂,解决了水溶肥中中微量元素不能添加的问题。稀土多元螯合肥
能够激活土壤活性,满足并平衡了植物生长期对所有养分需求。N、P、K “三元素”投入量减少30%-50%,而且保证了产量,产品质量提高5%-15%,土壤质量大大改善。



2.高嗜热菌技术
2018公司启动建设微生物工程研发中心,2019年试投产。现已完成各种功能菌剂筛选8个,形成复合菌剂2个(高嗜热复合微生物菌剂、解磷钾固氮复合微生物菌剂)。高嗜热功能菌剂由多种功能菌、细菌、放线菌、酵母菌等菌株复配而制成。 具有适应各种不良环境的能力,更主要是在耐高低温(-30℃-300℃)和耐受高水分(80%)条件下快速繁殖、快速起温、繁殖并腐解生物体。菌群繁殖具有培养基专一性、协调互补性强。形成发明专利两项:“一种解磷、钾固氮复合微生物功能菌肥及其制备方法”(专利号:CN201810541033.5),“一种复合微生物菌剂、生物有机肥及其制备方法和应用”(专利号:CN201910269687.1)并获澳大利亚革新专利授权(授权号2020100160)。高嗜热菌剂技术分为两大系列产品:有机肥系列和微生物菌剂系列。

我公司研发的生物有机肥是针对我国颗粒有机肥生产设备水平低、集成创新不足而研发的具有自主知识产权的新技术、新产品。主要原料为恒天然奶牛养殖牧场的牛粪,经自主研发的发酵菌剂发酵后作为有机肥原料。通过2年的研究,目前已完成中试,形成生产规模,设计年产20万吨,颗粒产品直径2.5-4毫米,抗压强度大于10N,与复合肥抗压强度相当。形成专利两项:一种组合有机肥造粒设备(专利号ZL201821092137.4)和一种有机肥生产线水分添加控制系统装置造粒设备(专利号ZL201820879959.0)。
产品特点为:有效活菌数高、适应性广、抗逆性强,具有固氮、解磷、解钾的功能;促进农作物生长,对各种作物均具有显著的稳产、增产效果;可促进作物活秆成熟,并提高作物的抗病能力提高作物品质,增加蛋白质、氨基酸和中微量元素含量,减轻作物中亚硝酸盐的含量;活化土壤,减轻土壤板结,达到肥田养地的目的;适合机械化作业使用。
3.土壤改良技术
盐碱地系列:基于我国盐碱地现状和解决我国土壤病态问题,公司技术研发中心结合日本和韩国技术,与中国农业大学和华北理工大学技术专家合作,根据盐碱地的特性,通过土壤采集、分析实验。对比结合大量的田间实验,研制出适合治理盐碱地土壤的全新产品-沣田宝双螯合盐碱改良剂,盐碱地形成原理是,盐随水来,水散盐留,盐溶于水,随水下沉。盐碱地治理的最大难点是,水分蒸发后,盐却留在土壤中,形成反复治理,反复上返。我们采取的是“干种湿出法”,利用的是“晶格水膜限透”技术,盐碱地改良剂随水下沉后,在土壤中形成晶格水膜,阻隔盐碱重复上返,将作物根系周围形成盐碱的阴阳离子降低至适合农作物生长的浓度,从而起到了治理盐碱的作用。该产品分为5kg、20kg和吨桶三种,具有抗盐压碱、提苗促根、钙镁搭配、固果提糖等功效。